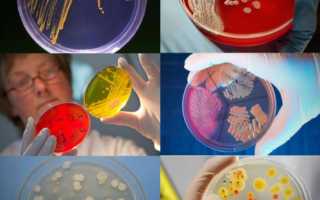

Мы живем в мире бактерий. Они вокруг нас и внутри нашего организма. Не удивительно, что мы хотим знать о них как можно больше. Но как рассмотреть и тем более изучить что-то настолько маленькое? Микроскоп, казалось бы, должен решить эту проблему. Но не все так просто – в своем естественном состоянии микроорганизмы прозрачны как стекло. «Проявить» картинку помогают различные методы окраски бактерий, помогающие исследовать внешнее и внутреннее строение микробов.
Как все начиналось
В конце девятнадцатого века датский биолог Кристиан Грам предложил решение этой проблемы. Если что-то невидимо, его нужно покрасить и посмотреть, что получится. Метод окраски бактерий, предложенный Грамом, был настолько убедителен, что и по сей день микроорганизмы разделяют на грамположительные (удерживающие окраску) и грамотрицательные (обесцвечивающиеся после обработки спиртом).
Как оказалось, клетки покрыты оболочкой, похожей на переплетенные между собой нити. И хотя в просветы между нитями свободно проходят питательные вещества, необходимые клетке, оболочка надежно защищает «внутренний мир» от внешних агрессивных факторов. У разных видов бактерий наружная стенка клетки имеет различную толщину, плотность и химический состав. Именно на этом свойстве клеточных оболочек базируется метод окраски по Граму.
Отталкиваясь от работ Кристиана Грама, биологи разработали новые методы, позволяющие не только определить форму и размер клеток, но и рассмотреть некоторые подробности их строения. Иногда микроорганизмы, совершенно идентичные по внешнему виду, по-разному реагируют на красители. Полученная информация дает возможность быстро и точно определить вид бактерий.
Врачи и микробиологи единодушны в том, что методы окраски микроорганизмов играют ключевую роль в диагностике инфекционных заболеваний. Окрашивание позволяет визуализировать бактерии и грибы под микроскопом, что значительно упрощает их идентификацию. Наиболее распространённые методы, такие как окраска по Граму, помогают разделить микроорганизмы на грамположительные и грамотрицательные, что имеет важное значение для выбора антибиотикотерапии. Врачи отмечают, что использование специальных красителей, таких как метиленовый синий или сафранин, позволяет выявлять даже те микроорганизмы, которые трудно поддаются визуализации. Современные технологии, включая флуоресцентную микроскопию, открывают новые горизонты в исследовании микробной жизни, позволяя детально изучать структуру и функции клеток. Таким образом, методы окраски не только облегчают диагностику, но и способствуют углублённому пониманию микробиологии.

Старый – не значит плохой
Пожалуй, самый практичный и широко применяемый способ окрашивания микроорганизмов – метод Грама. Мазок, зафиксированный огнем, покрывают метиловым фиолетовым красителем, фиксируют йодом, просушивают и промывают спиртом. На этом этапе, в зависимости от свойств клеточной мембраны, бактерии становятся:
- ярко-синими (грамположительные);
- бесцветными (грамотрицательные).
Толщина оболочки клеток, оставшихся бесцветными, не позволяет краске проникнуть внутрь, и она легко смывается с поверхности бактерий. Последним шагом окрашивания по Граму является использование красного красителя, он остается на поверхности клеточной мембраны и придает ей розовый или красный оттенок.
Грамположительные бактерии, как правило, опасны для человека. К этой категории относятся стрептококки, стафилококки, бациллы, клостридии и т. д. Грамотрицательные не настолько опасны. Они тоже могут вызывать болезни и воспаления, но только при определенных условиях. Таким образом, просто приготовив окрашенный препарат, можно получить представление о степени опасности исследуемых микроорганизмов.
Витальные методы окраски
По состоянию исследуемых организмов в микробиологии существуют:
- витальный способ, т. е. работа с живыми бактериями (опасен, требует строгого соблюдения техники безопасности);
- поствитальный метод – работа с фиксированными (убитыми) клетками;
- негативный, может быть витальным и поствитальным, удобен для работы с капсулами.
Витальный метод, безусловно, самый опасный, так как исследователям приходится иметь дело с живыми клетками, иногда представляющими смертельную опасность. Однако именно такой способ дает возможность изучать не только строение клетки, но и весь ее жизненный цикл и взаимодействие с окружением.
Для многих микробиологических исследований важно сохранить бактерии живыми. Это значит, что нужно использовать специальные нетоксичные или низкотоксичные красители, к тому же легко проникающие в структуру клетки через наружную оболочку. Это так называемые витальные красители, они могут быть предназначены для видимого света или флуоресцентными. По химическому составу красители разделяются на:
- основные (акридиновый оранжевый, метиленовый синий);
- кислотные или кислые (индигокармин, кислый фуксин);
- нейтральные (родамин В).
Методы окраски микроорганизмов играют ключевую роль в микробиологии, позволяя ученым визуализировать и изучать микроскопические организмы. Многие исследователи отмечают, что правильная окраска помогает не только в идентификации бактерий, но и в понимании их структуры и функции. Например, метод Грамма, разделяющий микроорганизмы на грамположительные и грамотрицательные, стал основой для диагностики инфекционных заболеваний.
Некоторые ученые подчеркивают, что использование флуоресцентных красителей открывает новые горизонты в изучении живых клеток, позволяя наблюдать за их поведением в реальном времени. Однако, несмотря на достижения, остаются и вызовы: необходимость в стандартизации методов и точности окраски, чтобы избежать ложных результатов. В целом, обсуждения вокруг методов окраски подчеркивают их важность в научных исследованиях и клинической практике, открывая новые возможности для понимания микромира.

Работа с фиксированными препаратами
По сложности работы методы окраски фиксированных (неживых) клеток разделяются на:
- Простые методы. В этом случае используют только одну краску, как правило, красную (фуксин) или синюю (метиленовый синий). Разница между этими красителями состоит в скорости воздействия. Фуксин дает результат уже через 1-2 мин., тогда как результат работы синей краски нужно ждать 3-5 мин. Использовать раствор фуксина в карболовой кислоте (т. н. фуксин Циля) удобно еще и потому, что приготовленный препарат в течение нескольких месяцев не теряет окрашивающих свойств. Метиленовый синий краситель тоже может быть подготовлен заранее в крепком спиртовом растворе.
- Сложные (дифференциальные) методы. Здесь потребуется несколько красителей (минимум два), имеющих различный цвет. Это позволит не просто увидеть бактерии, но и подробнее изучить их внутреннее строение, так как различные участки клетки могут по-разному воспринимать красители. К сложным относят методы Грама, Циля – Нильсена (для кислотоустойчивых бактерий), Бениньетти (окраска бактериальных жгутиков), Гинса (выявление капсул), дифференцирующий метод Романовского – Гимзы (окраска спор) и некоторые другие.
Особенно важны сложные методы для диагностики инфекционных заболеваний, например, способ окраски Нейссера помогает отличить дифтерийную палочку от ложнодифтерийных.
Дифференцирующий способ Романовского – Гимзы основан на применении специального готового порошка, на основе которого лаборатории готовят раствор красителя нужной концентрации. Преимущество этого способа в том, что цитоплазма и ядро клетки получают различную окраску, что облегчает идентификацию и изучение микроорганизмов.
Метод Нейссера используют в медицине для обнаружения зерен волютина (гранул с запасом пищи для многих прокариотических клеток) у возбудителей дифтерии. В результате окрашивания бактерия приобретает желтый цвет, а гранулы волютина – синий.
Белым по черному
Еще одна разновидность окраски бактерий основана на свойствах негатива, т. е. на темном фоне препарата четко видны бесцветные бактерии, иными словами, окрашивается среда, а не сам организм.
Иногда бактерии, попадая в определенные условия, образуют капсулы. Это слизистые образования, покрывающие клетку, чем-то похожие на гель. Капсулы прозрачны, их химический состав может сильно отличаться у разных видов бактерий, т.е. просто покрасить и оценить результат по получившемуся цвету не выйдет.
Кроме того, капсулы мягкие и непрочные, при окраске они могут потерять форму. Красящие вещества плохо взаимодействуют с желеобразной структурой капсул и легко вымываются при обработке. Чтобы обнаружить, но не повредить капсулы, пригодится негативный способ окрашивания.
Одним из способов выявления капсул является метод окрашивания по Гинсу. Каплю черной туши наносят на край предметного стекла, вносят в нее исследуемый материал, перемешивают и распределяют по всей поверхности. Мазок сушат на воздухе, фиксируют и окрашивают фуксином Циля. Через 2-3 минуты промывают водой и высушивают. В результате под микроскопом на общем темном фоне отчетливо просматриваются розовые клетки, окруженные прозрачными капсулами.

Окраска спорообразующих бактерий
Если говорить о клеточных оболочках, то нельзя не вспомнить о спорообразующих бактериях. Споры образуются при неблагоприятных для клетки условиях и могут существовать в агрессивной среде довольно длительное время. То, что хорошо для сохранения клетки, плохо для ее изучения. Споры очень плотные и почти не пропускают жидкости, кроме того, они кислотоустойчивы. Следовательно, простое окрашивание или метод Грама оставят споры бесцветными.
Перед началом окрашивания приходится химически обрабатывать поверхность спор, чтобы она немного изменила свою структуру и позволила красящим веществам проникнуть внутрь. При этом окрашивается и вся цитоплазма клетки. Чтобы обесцветить цитоплазму, препарат промывают и высушивают. Краска в спорах, благодаря их более плотной структуре задерживается лучше, чем в цитоплазме.
Способы окраски спор могут быть разными, например, Ожешко или Циля – Нильсена, но все они сводятся к одной схеме:
- разрыхление поверхности спор химическими веществами (кислоты, аммиак, едкий натр);
- окрашивание клетки со спорой (обычно при нагревании);
- обесцвечивание цитоплазмы.
В результате получаем отлично видимую ярко окрашенную спору и бледную, почти прозрачную цитоплазму.
Как рассмотреть бактериальные жгутики
Еще одна непростая задача – окраска бактерий со жгутиками. Это спирально закрученные очень тонкие нити, которые микроорганизмы используют для перемещения. Жгутики необычайно тонкие, при окрашивании они легко отрываются от клетки. Поэтому перед началом окрашивания жгутики протравливают, искусственно увеличивая в объеме.
При подготовке микроорганизмов к исследованию бактериальную культуру несколько раз пересеивают на свежую питательную среду в течение нескольких дней. Затем бактерии со жгутиками переносят в пробирку со стерильной водой (t 37⁰С). Делают это предельно осторожно, не перемешивая жидкость, чтобы не повредить жгутики.
Содержимое пробирки оставляют примерно на час, чтобы бактерии равномерно распределились по всему объему. Перед началом исследования проверяют подвижность клеток в висячей капле. Если движения нет, пробирку оставляют еще на некоторое время.
При нанесении раствора на предметное стекло клетки могут легко потерять жгутики. Поэтому поверхность стекла должна быть идеально чистой и обезжиренной. Перед нанесением капель раствора предметное стекло проводят над горячей частью пламени горелки, чтобы попавшие на поверхность капли расплылись и быстро высохли.
После высыхания мазок протравливают, через 15 минут химикат смывают. Следующий этап – окраску фуксином – проводят, погружая стекло в раствор красителя, чтобы не повредить жгутики при нанесении краски.
Выдержав нужное время, мазок промывают водой и высушивают. Теперь можно переходить к исследованию получившегося результата.
Техника окрашивания
Для получения окрашенного препарата нельзя просто взять кисточку, краски и отловить бактерию. Существует определенная схема работы с микроорганизмами:
- Приготовление мазка. На предметное стекло (стерильное) наносят каплю воды, в которую затем бактериологической петлей вносят и распределяют по поверхности лабораторный материал.
- Высушивание. Лишняя жидкость высушивается либо естественным путем при комнатной температуре, либо мазок немного прогревается высоко над пламенем горелки.
- Фиксация. Мало просто убрать воду, нужно закрепить бактерии на предметном стекле. Для этого можно использовать огонь (несколько проходов над самой горячей частью пламени) или жидкость (спирт, ацетон). После такой обработки микроорганизмы быстрее впитывают краску.
- Непосредственно окрашивание. Краска должна полностью покрывать всю поверхность мазка. Выдержав нужное время (для каждого красителя свое), краску убирают и промывают препарат водой.
После высыхания (обычно естественным путем) полученный результат можно использовать по назначению.
Окрашивание микроорганизмов – это целая система методов, приемов, схем, направленных на обнаружение и распознавание клеток при помощи микроскопа. Ни одно медицинское исследование или научная работа в микробиологии не обходятся без предварительной подготовки и окраски изучаемого материала.
Вопрос-ответ
Каковы методы окрашивания микропрепаратов?
Окраска препаратов в микробиологии — это комплекс методов и приёмов для исследования внешнего и внутреннего строения микроорганизмов. Она позволяет различать виды микроорганизмов и определять их форму, размеры, строение, локализацию и взаимное расположение.
Какие методы окраски наиболее часто используются для окраски микроорганизмов?
Сложные методы окраски микроорганизмов широко используются при идентификации микроорганизмов. Из этих методов широкое распространение получили методы окраски Грамма, Циля-Нельсона, Романовского-Гимзы.
Советы
СОВЕТ №1
Перед началом окраски микроорганизмов обязательно ознакомьтесь с различными методами, такими как грамм-окрашивание или окраска по Цилю-Нильсену. Каждый метод подходит для определенных типов микроорганизмов и может дать разные результаты.
СОВЕТ №2
Используйте свежеприготовленные красители и следите за сроками их хранения. Устаревшие или неправильно хранящиеся красители могут привести к нечетким или неверным результатам окраски.
СОВЕТ №3
Обратите внимание на технику нанесения красителя. Равномерное распределение красителя по образцу и правильное время экспозиции могут существенно повлиять на качество окраски и видимость микроорганизмов под микроскопом.
СОВЕТ №4
Не забывайте о контроле качества. Используйте контрольные образцы, чтобы убедиться в правильности окраски и интерпретации результатов. Это поможет избежать ошибок в анализах и повысит надежность ваших исследований.